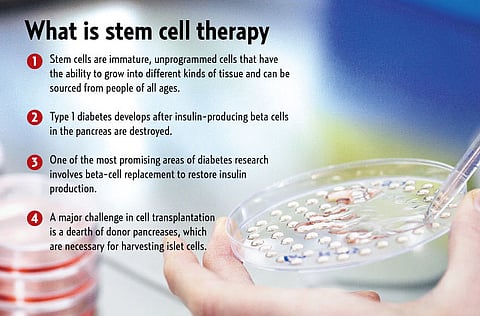
Gulf News

Stem cell therapy may open new window for diabetics
20% of the UAE's population currently suffers from the disease
Dubai: Stem cell therapy offers hope to a large number of UAE residents who are suffering from the debilitating condition of diabetes, a senior doctor from the Dubai Health Authority (DHA) said.
A task force had been set up for this therapy to be practised here, Dr Laila Al Jasmi, CEO for Health Policy and Strategy at the DHA, told participants at a seminar on Wednesday night.
"It offers hope for our people and the community around the region," she said.
UAE has the second-largest number of diabetics in the world after Nauru, a tiny Pacific island nation.
About 20 per cent of the UAE population suffers from the disease. Across the Gulf states there are 3.5 million diabetics.
The seminar, titled "Stem Cells Therapy in Diabetes, Is it a dream or a reality?, was organised by Joslin Diabetes Centre.
Stem cell therapy involves transplanting insulin producing cells from a donor pancreas into a patient.
Cadavers wanted
If it can help control the blood sugar level it will remove the need for insulin injections for patients with Type 1 diabetes, scientists said. But they noted that it will require large number of cadavers for harvesting the cells from the pancreas.
In Type 1 or juvenile-onset diabetes the body completely stops producing any insulin. Philippe Halban, Chairman of the European Foundation for the Study of Diabetes, said the recent revision of UAE's laws regarding organ donation brings a whole new perspective to stem cell therapy. He added, however, that there will never be enough organs to satisfy need.
He warned against "medical tourism" and cited the case of testimonials from a nightclub owner who underwent therapy in Peru and claimed he does not need any insulin injections. "Don't be mislead by such dangerous adverts," he said. "The research into stem cell therapy is still in its infancy," he said.
Type 2 diabetic patients have half the number of insulin producing cells, Dr Gordan C. Weir, head, section of Islet transplantation and cell biology at the Joslin Diabetes Center in Boston, US, said.
He said millions of dollars are being spent in research to find a cure for diabetes. He warned that within the next 10 years there would be between 300 to 400 diabetics across the globe. He blamed the agriculture revolution saying that people are eating more and obesity is up.
"Wherever obesity is high, diabetes follows," he said. "Exercise, lose weight," Weir, who is also the professor of medicine at the Harvard Medical School, said.
Beta cell factor
Stem cells are immature, unprogrammed cells that have the ability to grow into different kinds of tissue and can be sourced from people of all ages.
Type 1 diabetes develops after insulin-producing beta cells in the pancreas are destroyed.
One of the most promising areas of diabetes research involves beta cell replacement to restore insulin production.
A major challenge in cell transplantation is a dearth of donor pancreases, which are necessary for harvesting islet cells.


